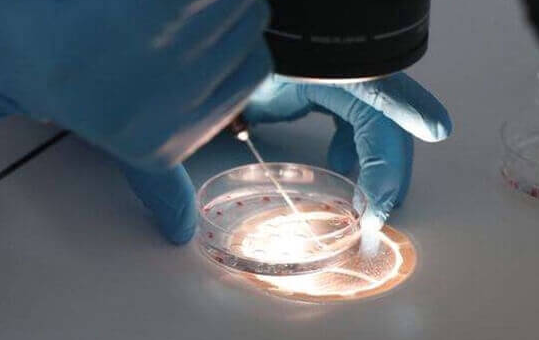

在试管婴儿治疗中,养囊是将受精卵培养至囊胚阶段的关键步骤,通常这一过程在受精后5至7天内完成。然而,部分患者会遇到养囊第6天才成功的情况,这背后往往与精子和卵子的质量密切相关。
精卵质量是养囊成功的基石。优质的精子和卵子是形成健康胚胎的基础。当精子或卵子的质量不佳时,受精卵的发育潜能会受到显著影响。例如,精子若存在染色体异常、活力低下或形态异常等问题,会降低受精成功率,即使成功受精,胚胎也可能因遗传物质缺陷而在早期发育阶段停滞。同样,卵子若存在染色体异常、线粒体功能不足或透明带异常等问题,也会影响胚胎的持续分裂和囊胚形成。
发育潜能低导致养囊时间延长。部分受精卵虽然能够成功受精,但由于发育潜能较低,分裂速度较慢,因此需要更长时间才能发育至囊胚阶段。这种情况下,养囊第6天才成功是胚胎自身发育特性的体现,而非实验室操作或培养环境的问题。
实验室条件与养囊技术的影响。尽管精卵质量是养囊成功的核心因素,但实验室条件和养囊技术同样不可忽视。稳定的温度、湿度、气体浓度以及无菌环境是胚胎健康发育的必要条件。此外,胚胎师的操作技巧、培养液的成分和更换时机等也会影响养囊结果。然而,即使在最理想的实验室条件下,若精卵质量不佳,养囊成功率仍会受到限制。
养囊第6天成功的胚胎质量如何?
实际上,养囊第6天成功并不意味着胚胎质量差。囊胚的评级需综合考虑其扩张程度、内细胞团和滋养层细胞的质量。部分第6天囊胚若评级较高(如Aa、Ab或Ba级),仍具有较高的着床率和妊娠率。








